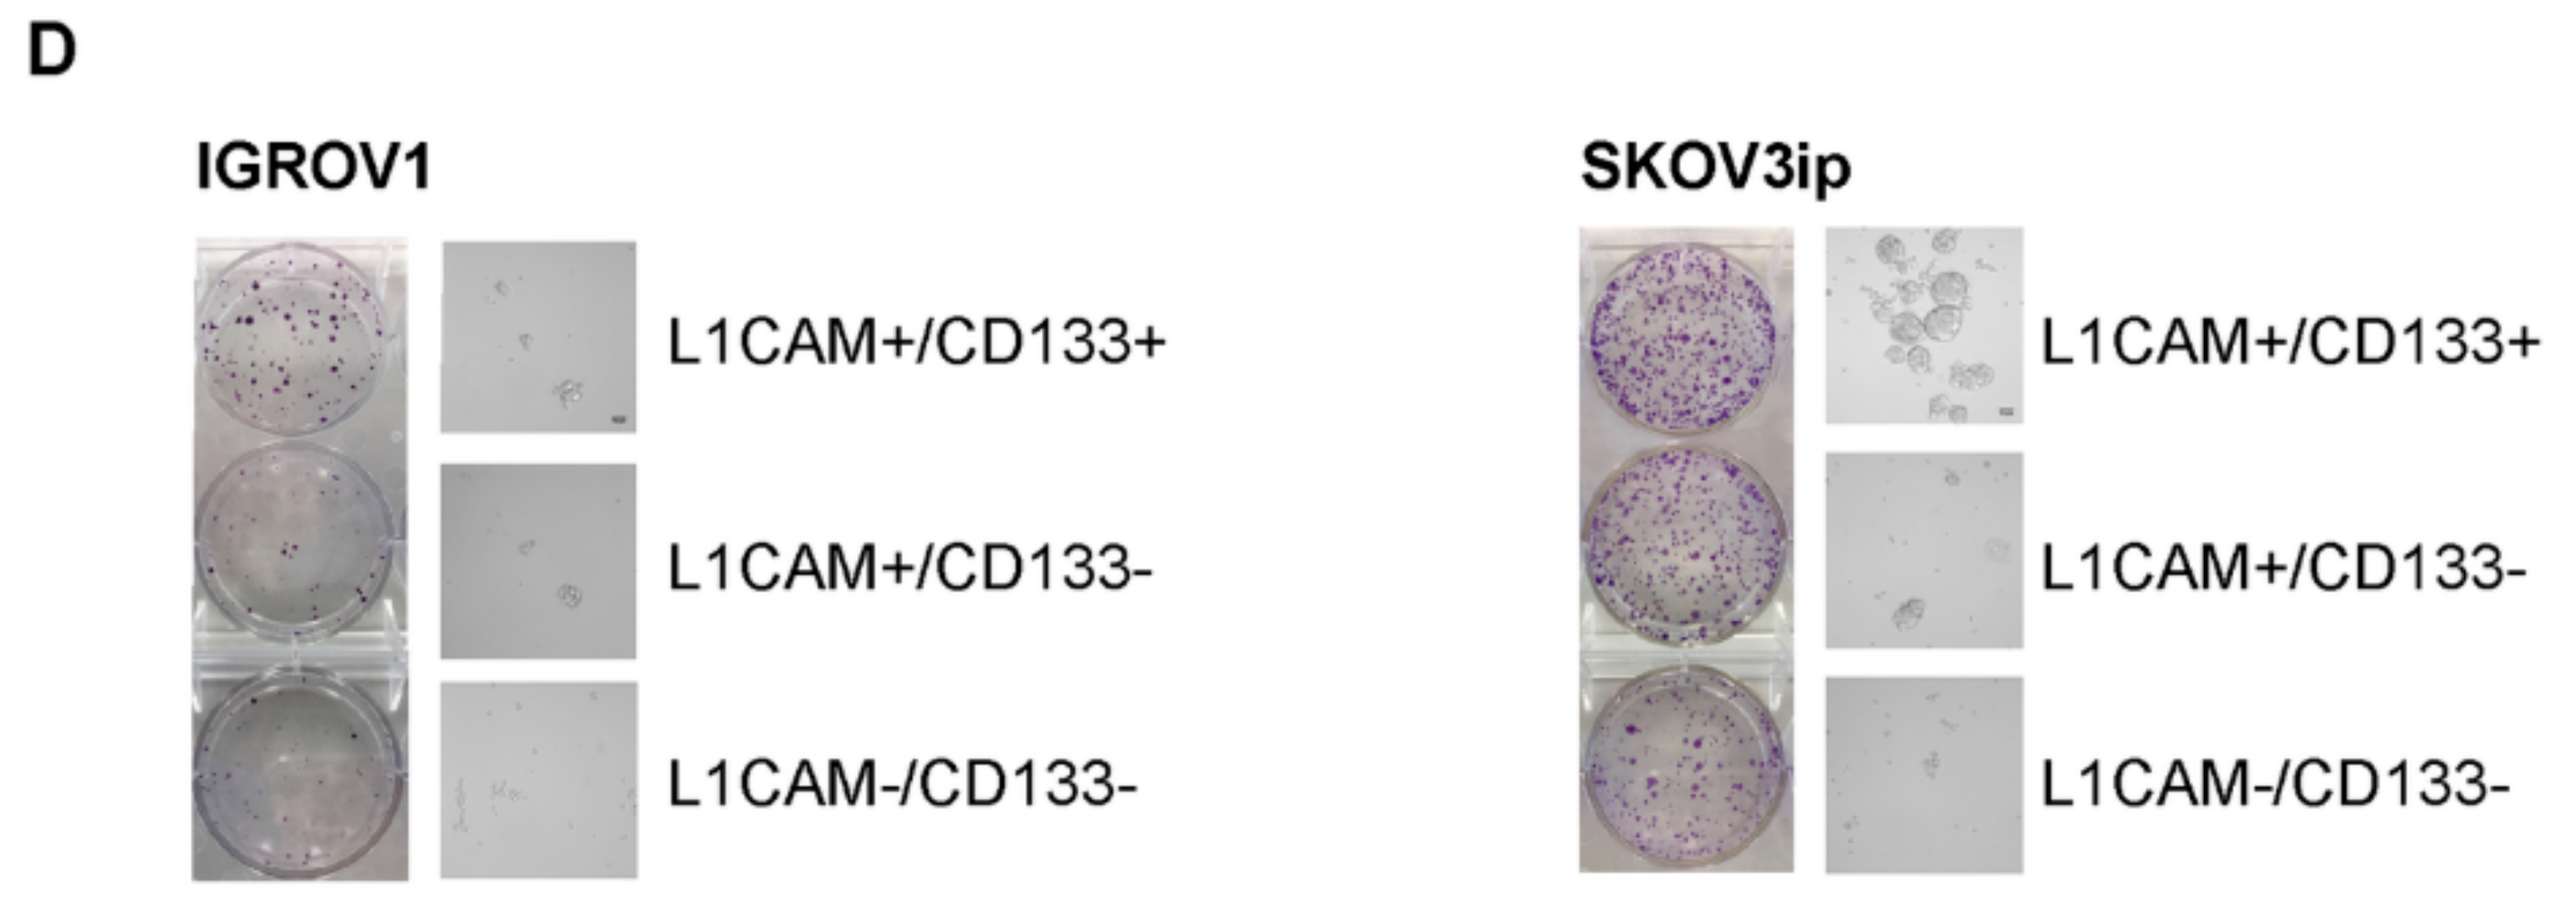
Cancers 12 00217 g001b Cancers 12 00217 g001b

L1 Cell Adhesion Molecule Confers Radioresistance to Ovarian Cancer and Defines a New Cancer Stem Cell Population
Abstract
1. Introduction
2. Results
2.1. L1CAM+/CD133+ Ovarian Cancer Cells Show the Highest Clonogenic and Spherogenic Properties as Well as Radioresistance
2.2. L1CAM Triggers Radioresistance in L1CAM+/CD133+ Population
2.3. L1CAM+/CD133+ Cells Have Higher Tumor Take, Fast Tumor Growth and Self-Renewal Capacity In Vivo
2.4. L1CAM Expression Coincides with Epithelial and Intermediate EMT Phenotypes in Ovarian Cancer Cell Lines
2.5. L1CAM Regulates the Expression of Stemness and EMT-Associated Genes
2.6. Human Ovarian Cancer Ascites Samples and Ovarian Cancer Cell Lines Display Heterogeneous Expression of Different Cell-Surface Markers
3. Discussion
4. Materials and Methods
4.1. Cell Culture
4.2. Flow Cytometry and Fluorescence-Activated Cell Sorting (FACS)
4.3. Clonogenic Assay
4.4. Radiation Responsiveness Assay
4.5. Sphere-Forming Assay
4.6. CRISPR-Cas9-Mediated Depletion of L1CAM
4.7. Quantitative Reverse Transcription PCR (RT-qPCR)
4.8. Human Xenograft Model
4.9. Statistical Analysis
5. Conclusions
Supplementary Materials
Author Contributions
Funding
Acknowledgments
Conflicts of Interest
References
- Matulonis, U.A.; Sood, A.K.; Fallowfield, L.; Howitt, B.E.; Sehouli, J.; Karlan, B.Y. Ovarian cancer. Nat. Rev. Dis. Primers 2016, 2, 16061. [Google Scholar] [CrossRef] [PubMed]
- Siegel, R.; Ward, E.; Brawley, O.; Jemal, A. Cancer statistics, 2011: The impact of eliminating socioeconomic and racial disparities on premature cancer deaths. CA Cancer J. Clin. 2011, 61, 212–236. [Google Scholar] [CrossRef]
- Jelovac, D.; Armstrong, D.K. Recent progress in the diagnosis and treatment of ovarian cancer. CA Cancer J. Clin. 2011, 61, 183–203. [Google Scholar] [CrossRef] [PubMed]
- Guarneri, V.; Piacentini, F.; Barbieri, E.; Conte, P.F. Achievements and unmet needs in the management of advanced ovarian cancer. Gynecol. Oncol. 2010, 117, 152–158. [Google Scholar] [CrossRef] [PubMed]
- Yap, T.A.; Carden, C.P.; Kaye, S.B. Beyond chemotherapy: Targeted therapies in ovarian cancer. Nat. Rev. Cancer 2009, 9, 167–181. [Google Scholar] [CrossRef] [PubMed]
- Westin, S.N.; Herzog, T.J.; Coleman, R.L. Investigational agents in development for the treatment of ovarian cancer. Investig. New Drugs 2013, 31, 213–229. [Google Scholar] [CrossRef]
- Bapat, S.A.; Mali, A.M.; Koppikar, C.B.; Kurrey, N.K. Stem and progenitor-like cells contribute to the aggressive behavior of human epithelial ovarian cancer. Cancer Res. 2005, 65, 3025–3029. [Google Scholar] [CrossRef]
- Reya, T.; Morrison, S.J.; Clarke, M.F.; Weissman, I.L. Stem cells, cancer, and cancer stem cells. Nature 2001, 414, 105–111. [Google Scholar] [CrossRef]
- Cojoc, M.; Mäbert, K.; Muders, M.H.; Dubrovska, A. A role for cancer stem cells in therapy resistance: Cellular and molecular mechanisms. Semin. Cancer Biol. 2015, 31, 16–27. [Google Scholar] [CrossRef]
- Curley, M.D.; Therrien, V.A.; Cummings, C.L.; Sergent, P.A.; Koulouris, C.R.; Friel, A.M.; Roberts, U.J.; Seiden, M.V.; Scadden, D.T.; Rueda, B.R.; et al. CD133 Expression Defines a Tumor Initiating Cell Population in Primary Human Ovarian Cancer. Stem Cells 2009, 27, 2875–2883. [Google Scholar] [CrossRef]
- Glumac, P.M.; Lebeau, A.M. The role of CD133 in cancer: A concise review. Clin. Transl. Med. 2018, 7, 18. [Google Scholar] [CrossRef] [PubMed]
- Ruscito, I.; Castillo-Tong, D.C.; Vergote, I.; Ignat, I.; Stanske, M.; Vanderstichele, A.; Ganapathi, R.N.; Glajzer, J.; Kulbe, H.; Trillsch, F.; et al. Exploring the clonal evolution of CD133/aldehyde-dehydrogenase-1 (ALDH1)-positive cancer stem-like cells from primary to recurrent high-grade serous ovarian cancer (HGSOC). A study of the Ovarian Cancer Therapy–Innovative Models Prolong Survival (OCTIPS) Consortium. Eur. J. Cancer 2017, 79, 214–225. [Google Scholar] [PubMed]
- Altevogt, P.; Doberstein, K.; Fogel, M. L1CAM in human cancer. Int. J. Cancer 2016, 138, 1565–1576. [Google Scholar] [CrossRef]
- Grünberg, J.; Lindenblatt, D.; Dorrer, H.; Cohrs, S.; Zhernosekov, K.; Köster, U.; Türler, A.; Fischer, E.; Schibli, R. Anti-L1CAM radioimmunotherapy is more effective with the radiolanthanide terbium-161 compared to lutetium-177 in an ovarian cancer model. Eur. J. Nucl. Med. Mol. Imaging 2014, 41, 1907–1915. [Google Scholar] [CrossRef] [PubMed]
- Lindenblatt, D.; Terraneo, N.; Pellegrini, G.; Cohrs, S.; Spycher, P.R.; Vukovic, D.; Béhé, M.; Schibli, R.; Grünberg, J. Combination of lutetium-177 labelled anti-L1CAM antibody chCE7 with the clinically relevant protein kinase inhibitor MK1775: A novel combination against human ovarian carcinoma. BMC Cancer 2018, 18, 922. [Google Scholar] [CrossRef] [PubMed]
- Kiefel, H.; Bondong, S.; Hazin, J.; Ridinger, J.; Schirmer, U.; Riedle, S.; Altevogt, P. L1CAM: A major driver for tumor cell invasion and motility. Cell Adhes. Migr. 2012, 6, 374–384. [Google Scholar] [CrossRef]
- Deng, J.; Wang, L.; Chen, H.; Hao, J.; Ni, J.; Chang, L.; Duan, W.; Graham, P.; Li, Y. Targeting epithelial-mesenchymal transition and cancer stem cells for chemoresistant ovarian cancer. Oncotarget 2016, 7, 55771–55788. [Google Scholar] [CrossRef]
- Brabletz, T.; Kalluri, R.; Nieto, M.A.; Weinberg, R.A. EMT in cancer. Nat. Rev. Cancer 2018, 18, 128–134. [Google Scholar] [CrossRef]
- Jacob, F.; Alam, S.; Konantz, M.; Liang, C.Y.; Kohler, R.S.; Everest-Dass, A.V.; Huang, Y.L.; Rimmer, N.; Fedier, A.; Schötzau, A.; et al. Transition of Mesenchymal and Epithelial Cancer Cells Depends on alpha1-4 Galactosyltransferase-Mediated Glycosphingolipids. Cancer Res. 2018, 78, 2952–2965. [Google Scholar] [CrossRef]
- Liu, X.Q.; Fan, D.M. The epithelial-mesenchymal transition and cancer stem cells: Functional and mechanistic links. Curr. Pharm. Des. 2015, 21, 1279–1291. [Google Scholar] [CrossRef]
- Kiefel, H.; Bondong, S.; Pfeifer, M.; Schirmer, U.; Erbe-Hoffmann, N.; Schäfer, H.; Sebens, S.; Altevogt, P. EMT-associated up-regulation of L1CAM provides insights into L1CAM-mediated integrin signalling and NF-κB activation. Carcinogenesis 2012, 33, 1919–1929. [Google Scholar] [CrossRef]
- Bao, S.D.; Wu, Q.L.; Li, Z.Z.; Sathornsumetee, S.; Wang, H.; McLendon, R.E.; Hjelmeland, A.B.; Rich, J.N. Targeting cancer stem cells through L1CAM suppresses glioma growth. Cancer Res. 2008, 68, 6043–6048. [Google Scholar] [CrossRef] [PubMed]
- Lee, J.M.; Mhawech-Fauceglia, P.; Lee, N.; Parsanian, L.C.; Lin, Y.G.; Gayther, S.A.; Lawrenson, K. A three-dimensional microenvironment alters protein expression and chemosensitivity of epithelial ovarian cancer cells in vitro. Lab. Investig. 2013, 93, 528–542. [Google Scholar]
- Elias, K.M.; Emori, M.M.; Papp, E.; Macduffie, E.; Konecny, G.E.; Velculescu, V.E.; Drapkin, R. Beyond genomics: Critical evaluation of cell line utility for ovarian cancer research. Gynecol. Oncol. 2015, 139, 97–103. [Google Scholar] [CrossRef] [PubMed]
- O’Brien, C.; Kreso, A.; Jamieson, C.H.M. Cancer Stem Cells and Self-renewal. Clin. Cancer Res. 2010, 16, 3113–3120. [Google Scholar] [CrossRef] [PubMed]
- Al-Alem, L.F.; Pandya, U.M.; Baker, A.T.; Bellio, C.; Zarrella, B.D.; Clark, J.; DiGloria, C.M.; Rueda, B.R. Ovarian cancer stem cells: What progress have we made? Int. J. Biochem. Cell Biol. 2018, 107, 92–103. [Google Scholar] [CrossRef]
- Lupia, M.; Cavallaro, U. Ovarian cancer stem cells: Still an elusive entity? Mol. Cancer 2017, 16, 64. [Google Scholar] [CrossRef]
- Huang, R.Y.J.; Wong, M.K.; Tan, T.Z.; Kuay, K.T.; Ng, A.H.C.; Chung, V.Y.; Chu, Y.S.; Matsumura, N.; Lai, H.C.; Lee, Y.F.; et al. An EMT spectrum defines an anoikis-resistant and spheroidogenic intermediate mesenchymal state that is sensitive to e-cadherin restoration by a src-kinase inhibitor, saracatinib (AZD0530). Cell Death Dis. 2013, 4, e915. [Google Scholar] [CrossRef]
- Mitra, T.; Prasad, P.; Mukherjee, P.; Chaudhuri, S.R.; Chatterji, U.; Roy, S.S. Stemness and chemoresistance are imparted to the OC cells through TGFbeta1 driven EMT. J. Cell. Biochem. 2018, 119, 5775–5787. [Google Scholar] [CrossRef]
- Ishiguro, T.; Sato, A.; Ohata, H.; Ikarashi, Y.; Takahashi, R.U.; Ochiya, T.; Yoshida, M.; Tsuda, H.; Onda, T.; Kato, T.; et al. Establishment and Characterization of an In Vitro Model of Ovarian Cancer Stem-like Cells with an Enhanced Proliferative Capacity. Cancer Res. 2016, 76, 150–160. [Google Scholar] [CrossRef]
- Liao, J.Q.; Qian, F.; Tchabo, N.; Mhawech-Fauceglia, P.; Beck, A.; Qian, Z.K.; Wang, X.H.; Huss, W.J.; Lele, S.B.; Morrison, C.D.; et al. Ovarian Cancer Spheroid Cells with Stem Cell-Like Properties Contribute to Tumor Generation, Metastasis and Chemotherapy Resistance through Hypoxia-Resistant Metabolism. PLoS ONE 2014, 9, e84941. [Google Scholar] [CrossRef]
- Ishiguro, T.; Ohata, H.; Sato, A.; Yamawaki, K.; Enomoto, T.; Okamoto, K. Tumor-derived spheroids: Relevance to cancer stem cells and clinical applications. Cancer Sci. 2017, 108, 283–289. [Google Scholar] [CrossRef]
- Davidowitz, R.A.; Selfors, L.M.; Iwanicki, M.P.; Elias, K.M.; Karst, A.; Piao, H.; Ince, T.A.; Drage, M.G.; Dering, J.; Konecny, G.E.; et al. Mesenchymal gene program-expressing ovarian cancer spheroids exhibit enhanced mesothelial clearance. J. Clin. Investig. 2014, 124, 2611–2625. [Google Scholar] [CrossRef] [PubMed]
- Aiello, N.M.; Maddipati, R.; Norgard, R.J.; Balli, D.; Li, J.; Yuan, S.; Yamazoe, T.; Black, T.; Sahmoud, A.; Furth, E.E.; et al. EMT Subtype Influences Epithelial Plasticity and Mode of Cell Migration. Dev. Cell 2018, 45, 681–695. [Google Scholar] [CrossRef] [PubMed]
- Sowa, T.; Menju, T.; Sonobe, M.; Nakanishi, T.; Shikuma, K.; Imamura, N.; Motoyama, H.; Hijiya, K.; Aoyama, A.; Chen, F.; et al. Association between epithelial-mesenchymal transition and cancer stemness and their effect on the prognosis of lung adenocarcinoma. Cancer Med. 2015, 4, 1853–1862. [Google Scholar] [CrossRef] [PubMed]
- Jordan, N.V.; Johnson, G.L.; Abell, A.N. Tracking the intermediate stages of epithelial-mesenchymal transition in epithelial stem cells and cancer. Cell Cycle 2011, 10, 2865–2873. [Google Scholar] [CrossRef]
- Chaffer, C.L.; Juan, B.P.S.; Lim, E.; Weinberg, R.A. EMT, cell plasticity and metastasis. Cancer Metastasis Rev. 2016, 35, 645–654. [Google Scholar] [CrossRef]
- Doberstein, K.; Harter, P.N.; Haberkorn, U.; Bretz, N.P.; Arnold, B.; Carretero, R.; Moldenhauer, G.; Mittelbronn, M.; Altevogt, P. Antibody therapy to human L1CAM in a transgenic mouse model blocks local tumor growth but induces EMT. Int. J. Cancer 2015, 136, 326–339. [Google Scholar] [CrossRef]
- Lupia, M.; Angiolini, F.; Bertalot, G.; Freddi, S.; Sachsenmeier, K.F.; Chisci, E.; Kutryb-Zając, B.; Confalonieri, S.; Smolenski, R.T.; Giovannoni, R.; et al. CD73 Regulates Stemness and Epithelial-Mesenchymal Transition in Ovarian Cancer-Initiating Cells. Stem Cell Rep. 2018, 10, 1412–1425. [Google Scholar] [CrossRef]
- Strauss, R.; Li, Z.Y.; Liu, Y.; Beyer, I.; Persson, J.; Sova, P.; Möller, T.; Pesonen, S.; Hemminki, A.; Hamerlik, P. Analysis of epithelial and mesenchymal markers in ovarian cancer reveals phenotypic heterogeneity and plasticity. PLoS ONE 2011, 6, e16186. [Google Scholar] [CrossRef]
- Peng, S.; Maihle, N.J.; Huang, Y. Pluripotency factors Lin28 and Oct4 identify a sub-population of stem cell-like cells in ovarian cancer. Oncogene 2010, 29, 2153–2159. [Google Scholar] [CrossRef] [PubMed]
- Guo, Q.; Gao, B.L.; Zhang, X.J.; Liu, G.C.; Xu, F.; Fan, Q.Y.; Zhang, S.J.; Yang, B.; Wu, X.H. CXCL12-CXCR4 Axis Promotes Proliferation, Migration, Invasion, and Metastasis of Ovarian Cancer. Oncol. Res. 2014, 22, 247–258. [Google Scholar] [CrossRef] [PubMed]
- Kobayashi, Y.; Seino, K.I.; Hosonuma, S.; Ohara, T.; Itamochi, H.; Isonishi, S.; Kita, T.; Wada, H.; Kojo, S.; Kiguchi, K. Side population is increased in paclitaxel-resistant ovarian cancer cell lines regardless of resistance to cisplatin. Gynecol. Oncol. 2011, 121, 390–394. [Google Scholar] [CrossRef] [PubMed]
- Asem, M.S.; Buechler, S.; Wates, R.B.; Miller, D.L.; Stack, M.S. Wnt5a Signaling in Cancer. Cancers 2016, 8, 79. [Google Scholar] [CrossRef] [PubMed]
- Davidson, B.; Holth, A.; Hellesylt, E.; Tan, T.Z.; Huang, R.Y.J.; Trope, C.; Nesland, J.M.; Thiery, J.P. The clinical role of epithelial-mesenchymal transition and stem cell markers in advanced-stage ovarian serous carcinoma effusions. Hum. Pathol. 2015, 46, 1–8. [Google Scholar] [CrossRef]
- Rafehi, S.; Ramos Valdes, Y.; Bertrand, M.; McGee, J.; Prefontaine, M.; Sugimoto, A.; DiMattia, G.E.; Shepherd, T.G. TGFbeta signaling regulates epithelial-mesenchymal plasticity in ovarian cancer ascites-derived spheroids. Endocr. Relat. Cancer 2016, 23, 147–159. [Google Scholar] [CrossRef]
- Cao, L.; Shao, M.; Schilder, J.; Guise, T.; Mohammad, K.S.; Matei, D. Tissue transglutaminase links TGF-beta, epithelial to mesenchymal transition and a stem cell phenotype in ovarian cancer. Oncogene 2012, 31, 2521–2534. [Google Scholar] [CrossRef]
- Lv, Z.D.; Kong, B.; Li, J.G.; Qu, H.L.; Wang, X.G.; Cao, W.H.; Liu, X.Y.; Wang, Y.; Yang, Z.C.; Xu, H.M.; et al. Transforming growth factor-beta 1 enhances the invasiveness of breast cancer cells by inducing a Smad2-dependent epithelial-to-mesenchymal transition. Oncol. Rep. 2013, 29, 219–225. [Google Scholar] [CrossRef]
- Pang, M.F.; Georgoudaki, A.M.; Lambut, L.; Johansson, J.; Tabor, V.; Hagikura, K.; Jin, Y.; Jansson, M.; Alexander, J.S.; Nelson, C.M.; et al. TGF-beta1-induced EMT promotes targeted migration of breast cancer cells through the lymphatic system by the activation of CCR7/CCL21-mediated chemotaxis. Oncogene 2016, 35, 748–760. [Google Scholar] [CrossRef]
- Mima, K.; Hayashi, H.; Kuroki, H.; Nakagawa, S.; Okabe, H.; Chikamoto, A.; Watanabe, M.; Beppu, T.; Baba, H. Epithelial-mesenchymal transition expression profiles as a prognostic factor for disease-free survival in hepatocellular carcinoma: Clinical significance of transforming growth factor-beta signaling. Oncol. Lett. 2013, 5, 149–154. [Google Scholar] [CrossRef] [PubMed]
- Liu, Y.; Hu, H.; Wang, K.; Zhang, C.; Wang, Y.; Yao, K.; Yang, P.; Han, L.; Kang, C.; Zhang, W.; et al. Multidimensional analysis of gene expression reveals TGFB1I1-induced EMT contributes to malignant progression of astrocytomas. Oncotarget 2014, 5, 12593–12606. [Google Scholar] [CrossRef] [PubMed]
- Franken, N.A.P.; Rodermond, H.M.; Stap, J.; Haveman, J.; Van Bree, C. Clonogenic assay of cells in vitro. Nat. Protoc. 2006, 1, 2315–2319. [Google Scholar] [CrossRef] [PubMed]
- Alam, S.; Anugraham, M.; Huang, Y.L.; Kohler, R.S.; Hettich, T.; Winkelbach, K.; Grether, Y.; López, M.N.; Khasbiullina, N.; Bovin, N.V.; et al. Altered (neo-) lacto series glycolipid biosynthesis impairs alpha2-6 sialylation on N-glycoproteins in ovarian cancer cells. Sci. Rep. 2017, 7, 45367. [Google Scholar] [CrossRef] [PubMed]
- Kohler, R.S.; Anugraham, M.; López, M.N.; Xiao, C.; Schoetzau, A.; Hettich, T.; Schlotterbeck, G.; Fedier, A.; Jacob, F.; Heinzelmann-Schwarz, V. Epigenetic activation of MGAT3 and corresponding bisecting GlcNAc shortens the survival of cancer patients. Oncotarget 2016, 7, 51674–51686. [Google Scholar] [CrossRef] [PubMed]
- Fischer, E.; Grünberg, J.; Cohrs, S.; Hohn, A.; Waldner-Knogler, K.; Jeger, S.; Zimmermann, K.; Novak-Hofer, I.; Schibli, R. L1-CAM-targeted antibody therapy and (177)Lu-radioimmunotherapy of disseminated ovarian cancer. Int. J. Cancer 2012, 130, 2715–2721. [Google Scholar] [CrossRef]
- Lindenblatt, D.; Fischer, E.; Cohrs, S.; Schibli, R.; Grünberg, J. Paclitaxel improved anti-L1CAM lutetium-177 radioimmunotherapy in an ovarian cancer xenograft model. EJNMMI Res. 2014, 4, 54. [Google Scholar] [CrossRef]

| DPOS | L1CAM+/CD133− | DNEG | Bulk | ||
|---|---|---|---|---|---|
| SKOV3ip | Dilution 1 | 2/3 (73–101) | 2/6 * (66–108) | 0/6 * | 1/6 * (59) |
| Dilution 2 | 3/3 (31–59) | 0/6 * | 0/6 * | 0/6 * | |
| Dilution 3 | 1/3 (44) | 0/6 * | 0/6 * | 1/6 * (59) | |
| IGROV1 | Dilution 1 | 6/6 (29–79) | 4/6 (36–82) | 4/6 (36–79) | 4/6 (43–149) |
| Dilution 2 | 5/6 (36–64) | 5/6 (36–124) | 4/6 (50–57) | 2/6 (33–85) | |
| Dilution 3 | 6/6 (29) | 4/6 (36–49) | 5/6 (71–96) | 4/6 (33–64) |
| L1CAM+/CD133+ | L1CAM+/CD133− | L1CAM−/CD133− | Bulk Population |
|---|---|---|---|
| 8/8 | 0/8 | 0/4 | 0/4 |
| Cell Line | L1CAM [%] | EMT Class | E-Cadherin | Vimentin |
|---|---|---|---|---|
| OVCAR4 | 98.2 ± 1.8 | E | +++ | − |
| OVCAR5 | 19.8 ± 4.2 | E | +++ | − |
| CAOV3 | 99.3 ± 1 | E | ++ | − |
| OVSAHO | 98.6 ± 1.2 | E | +++ | − |
| BG1 | 9.1 ± 5.3 | E | ++ | + |
| OAW42 | 98.9 ± 1.1 | IE | ++ | + |
| IGROV1 | 99.9 ± 0.1 | IE | ++ | − |
| SKOV3ip | 88.2 ± 0.1 | IE | ++ | + |
| OVCAR8 | 91.4 ± 8.5 | IM | − | n.d. |
| Kuramochi | 81 ± 5.4 | IM | + | ++ |
| EFO27 | 98.6 ± 1.4 | M | − | ++ |
| A2780 | 0.3 ± 0.1 | M | − | ++ |
| TYK-nu | 0.8 ± 0.3 | M | − | ++ |
| TOV112D | 2.3 ± 0.8 | M | − | ++ |
© 2020 by the authors. Licensee MDPI, Basel, Switzerland. This article is an open access article distributed under the terms and conditions of the Creative Commons Attribution (CC BY) license (http://creativecommons.org/licenses/by/4.0/).
Share and Cite
Terraneo, N.; Jacob, F.; Peitzsch, C.; Dubrovska, A.; Krudewig, C.; Huang, Y.-L.; Heinzelmann-Schwarz, V.; Schibli, R.; Béhé, M.; Grünberg, J. L1 Cell Adhesion Molecule Confers Radioresistance to Ovarian Cancer and Defines a New Cancer Stem Cell Population. Cancers 2020, 12, 217. https://doi.org/10.3390/cancers12010217
Terraneo N, Jacob F, Peitzsch C, Dubrovska A, Krudewig C, Huang Y-L, Heinzelmann-Schwarz V, Schibli R, Béhé M, Grünberg J. L1 Cell Adhesion Molecule Confers Radioresistance to Ovarian Cancer and Defines a New Cancer Stem Cell Population. Cancers. 2020; 12(1):217. https://doi.org/10.3390/cancers12010217
Chicago/Turabian StyleTerraneo, Nastassja, Francis Jacob, Claudia Peitzsch, Anna Dubrovska, Christiane Krudewig, Yen-Lin Huang, Viola Heinzelmann-Schwarz, Roger Schibli, Martin Béhé, and Jürgen Grünberg. 2020. "L1 Cell Adhesion Molecule Confers Radioresistance to Ovarian Cancer and Defines a New Cancer Stem Cell Population" Cancers 12, no. 1: 217. https://doi.org/10.3390/cancers12010217
APA StyleTerraneo, N., Jacob, F., Peitzsch, C., Dubrovska, A., Krudewig, C., Huang, Y.-L., Heinzelmann-Schwarz, V., Schibli, R., Béhé, M., & Grünberg, J. (2020). L1 Cell Adhesion Molecule Confers Radioresistance to Ovarian Cancer and Defines a New Cancer Stem Cell Population. Cancers, 12(1), 217. https://doi.org/10.3390/cancers12010217







